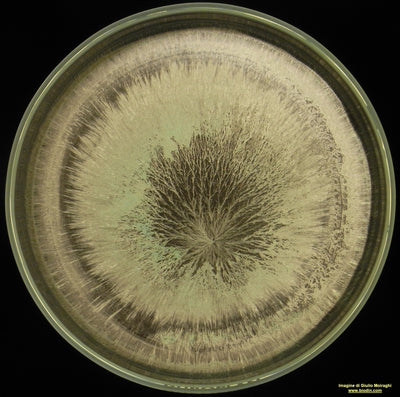
501 CORNOSILICE
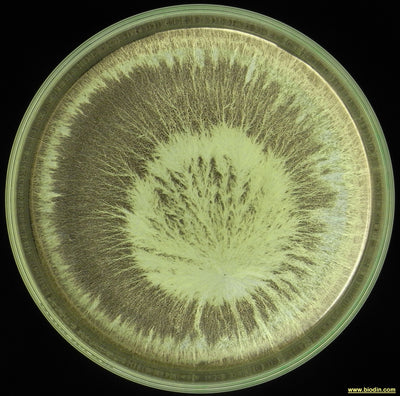
508 CORNO EQUISETO

12 NOTTI SANTE
Le 12 Notti Sante che vanno dal 24 di dicembre al 6 di gennaio sono un momento unico dell’anno dove si aprono le porte del mondo spirituale e dove possiamo ottenere importanti risultati d ottenere risposte uniche. Ne tratto nel mio ultimo libro “Il periodo astronomico del Capricorno, il Preparato di Argilla e le 12 Notti Sante” che potete ordinare qui.
Per chi ha coraggio, abnegazione e determinazione offro un calendario di trattamenti specifici per ogni giorno, trattamenti biodinamici che come una agopuntura darebbero risultati molto benefici, estesi e grandi anche sui terreni adiacenti a dove saranno dati. Rudolf Steiner disse che una goccia di preparato biodinamico dinamizzato e spruzzato sul suolo agisce fino a 500 metri di raggio da dove è caduto.
Ricordo che la Notte Santa inizia dalle ore 18,00 del giorno precedente e finisce alle ore 17,59 del giorno della Notte Santa.
Dato che i preparati che consiglio di usare nel periodo delle 12 Notti Sante agiscono sull’anima di gruppo dei minerali e dei vegetali si potrebbe dinamizzare anche solo per 40 minuti ogni preparato. Resta inteso che la dinamizzazione completa di 60 minuti è l’ideale. In ogni caso il preparato di Valeriana va dinamizzato solo per 20 minuti.
I trattamenti principali e fondamentali contraddistinti dagli asterischi rossi sono i fondamentali, ma se riusciste a farli tutti sarebbe un grandissimo regalo e riconoscimento per gli Esseri Elementari e per l’intera umanità!
Se nelle 12 notti Sante assumeremo alla sera un cucchiaino di polvere di LichtYam, (scopri di più) ci aiuterà a ricordare i sogni e relazionarci con gli esseri elementari.
- ***Apertura delle 12 Notti Sante 22 – 23 Dicembre ***
Dinamizzare solo per venti minuti e spruzzare il preparato di Valeriana (507), (scopri di più) nel pomeriggio
- *** Prima Notte Santa 24- 25 dicembre Ariete ***
Dinamizzare e spruzzare il cornosilice (501), (scopri di più) nel primo pomeriggio
- *** Seconda Notte Santa 25-26 Dicembre Toro ***
Dinamizzare e spruzzare nella tarda mattinata o pomeriggio (se il terreno è gelato) il cornoletame (500), (scopri di più)
- Terza Notte Santa 26-27 Dicembre Gemelli
Dinamizzare e spruzzare il preparato di Achillea (502), (scopri di più) nel pomeriggio
- Quarta Notte Santa 27 – 28 Dicembre Cancro
dinamizzare e spruzzare il preparato di Tarassaco (506), (scopri di più) nel pomeriggio
- *** Quinta Notte Santa 28 -29 Dicembre Leone ***
Dinamizzare e spruzzare il preparato di Ortica (504), (scopri di più) nel pomeriggio
- Sesta Notte Santa 29 – 30 Dicembre Vergine
Dinamizzare e spruzzare il preparato di Camomilla (503), (scopri di più) nel pomeriggio
- *** Settima Notte Santa (doppia) 30-31 dicembre e 31 dicembre – 1 gennaio ***
Dinamizzare e spruzzare il preparato del Calcio di H. Erbe, (scopri di più) nella Notte Santa del 30 e 31 dicembre nel pomeriggio
Dinamizzare e spruzzare il preparato di Corteccia di Quercia (505), (scopri di più) nella Notte Santa del 31 dicembre – 1 gennaio nel pomeriggio
- Ottava Notte Santa 1 -2 Gennaio
Dinamizzare spruzzare il preparato del Carbonio di H. Erbe , (scopri di più) nel pomeriggio
- Nona Notte Santa 2-3 Gennaio Sagittario
Dinamizzare e spruzzare il preparato di Latte e Miele di H. Erbe , (scopri di più) nel pomeriggio
- *** Decima Notte Santa 3-4 Gennaio Capricorno ***
Dinamizzare e spruzzare il preparato di Argilla (509), (scopri qui) nel pomeriggio
- Undicesima Notte Santa 4-5 Gennaio Acquario nel pomeriggio
- Dinamizzare e spruzzare il preparato di Equiseto (508), (scopri di più)
- *** 12 Notte Santa 5-6 gennaio Pesci ***
- Dinamizzare e spruzzare sui confini del nostro terreno il preparato del TKP, il preparato dei Tre Re di H. Erbe nel pomeriggio
Vi invito a bere qualche goccia del preparato dinamizzato in modo che agisca anche sugli esseri elementari della nostra interiorità.
È utile prima della dinamizzazione ed alla fine della spruzzatura leggere il mantram per i preparati biodinamici.